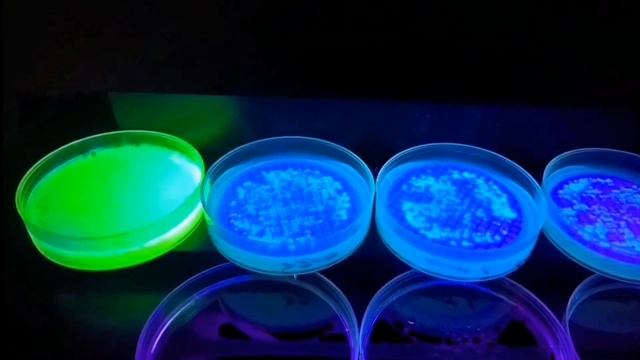
Pseudomonas Aeruginosa Identification And Laboratory Diagnosis (English) - Medical Microbiology

Diagnosis - видео
- ⌚ 05.10.2023 Diagnosis: Surprise ~ Mlp Creepypasta с 47- 60 части
- ⌚ 21.03.2024 Диагноз: Сюрприз - часть 46
- ⌚ 23.08.2023 LG Smart Diagnosis.
- ⌚ 03.11.2023 Mercedes Star Diagnosis C4 полный обзор
- ⌚ 16.11.2023 Diagnosis: Surprise ~ Mlp Creepypasta ( с 1 -16 части)
- ⌚ 17.11.2023 S. Lazarev, .. Diagnosis Of Karma .. С. Лазарев , .. Диагностика кармы..
- ⌚ 31.08.2016 Режим самодиагностики Ford Mondeo 4-The Self-diagnosis Mode Ford Mondeo 4
- ⌚ 14.08.2023 [LG ThinQ] Refrigerator Smart Diagnosis
- ⌚ 28.07.2024 Немного про батарейки. Fanuc Diagnosis 772.
- ⌚ 24.08.2024 диагностика опель это легко!opel Diagnosis опель астра H
- ⌚ 04.04.2022 Vertebral Artery Syndrome Symptoms, Treatment, Diagnosis, Causes
- ⌚ 14.01.2026 Smart Diagnosis LG. Настройка и работа на стиральной машине
- ⌚ 18.03.2024 Yamaha Prime Start Diagnosis
- ⌚ 28.02.2025 DIAGNOSIS & MANAGEMENT OF RHEGMATOGENOUS RETINAL DETACHMENT
- ⌚ 02.09.2024 New Technologies For Diagnosis And Treatment Of Gynecologic Diseases 2023. Day 2
- ⌚ 30.08.2024 New Technologies For Diagnosis And Treatment Of Gynecologic Diseases 2023. Day 1
- ⌚ 18.02.2026 Molecular Diagnosis For Infection Of The Skin, Hair And Nails
- ⌚ 04.09.2024 New Technologies For Diagnosis And Treatment Of Gynecologic Diseases 2023. Day 4
- ⌚ 09.08.2023 Washing Machine LG Smart Diagnosis❗? Стиральная машина LG функция Smart Diagnosis ?
- ⌚ 27.08.2024 New Technologies For Diagnosis And Treatment Of Gynecologic Diseases 2023. Day 3
- ⌚ 20.11.2015 DIAGNOSIS
- ⌚ 24.08.2024 Diagnosis: Multitude | Update 1.3.0 - Full Gameplay| Episode: Installation
- ⌚ 21.11.2023 Diagnosis: Surprise ~ Mlp Creepypasta (с 25-34 части)
- ⌚ 16.05.2024 The Diagnosis
- ⌚ 17.05.2024 The Diagnosis.
- ⌚ 30.11.2023 PHP BLOG #3 - DIFFERENTIAL DIAGNOSIS
- ⌚ 18.01.2024 Постановка диагноза. Diagnosis.
- ⌚ 07.02.2024 MERCEDES BENZ Star DIAGNOSE C3 D4 Diagnosis MULTIPLEXER
- ⌚ 04.05.2024 Understanding Fibrous Dysplasia: Causes, Diagnosis, Types, And Management
- ⌚ 24.04.2024 Diagnosis (short)/ Диагноз 2009
- ⌚ 21.12.2024 Smart Diagnosis Lg для стиральной машины настройка и запуск
- ⌚ 05.02.2025 Новая игра от разработчика Dread Teacher // Diagnosis: Multitude
- ⌚ 03.12.2023 Arrhythmias | Types, Pathophysiology, Diagnosis, Treatment
- ⌚ 19.12.2023 Dealing With A Childhood Cancer Diagnosis
- ⌚ 02.05.2024 Pertussis Diagnosis And Treatment | Respiratory System Diseases | NCLEX-RN | Khan Academy
- ⌚ 03.01.2025 D03_[General Differential Diagnosis]
- ⌚ 03.03.2024 C4 Mercedes-Benz Star Diagnosis - Guide - Live Diagnosis
- ⌚ 06.12.2023 Medical Zone Differential Diagnosis Of Actinomycosis
- ⌚ 13.10.2023 Mystery Diagnosis -- Behcet's Disease, Part 2 Of 2
- ⌚ 24.10.2023 ПРОХОЖДЕНИЕ DIAGNOSIS: MULTITUDE!!!!
- ⌚ 24.04.2024 Hepatitis B Virus Diagnosis
- ⌚ 08.10.2023 Обновление // Прохождение новых эпизодов // Diagnosis: Multitude 1.2
- ⌚ 16.01.2024 Диагностика печени © Liver Diagnosis
- ⌚ 20.12.2023 Diagnosis
- ⌚ 21.01.2024 Наше оборудование. Star Diagnosis, Launch, I Com, Вася диагност. Сканеры.
- ⌚ 08.10.2023 Прохождение нового Эпизода // Diagnosis: Multitude 1.3
- ⌚ 05.10.2024 Star Diagnosis - How To Work
- ⌚ 02.09.2024 Ethiological TB Diagnosis
- ⌚ 12.11.2023 ?ДИАГНОСТИКА НА СПИЧКАХ |DIAGNOSIS ON MATCHES ?
- ⌚ 11.01.2025 P0117 / P0118 Diagnosis And Explanation
- ⌚ 08.06.2018 Star Diagnosis SD Connect 4
- ⌚ 20.11.2024 Inflammation - Causes, Symptoms, Diagnosis, Treatment, Pathology
- ⌚ 28.11.2023 P0325 Knock Sensor Diagnosis - EricTheCarGuy
- ⌚ 16.01.2024 Обновление // Diagnosis: Multitude 1.1.0
- ⌚ 24.04.2024 Streptococcus Pyogen Laboratory Diagnosis
- ⌚ 08.10.2024 Honda P1399 Code Diagnosis Pt1
- ⌚ 01.05.2024 HPV(Disease,Diagnosis,Treatment)
- ⌚ 06.12.2023 Actinomyces In Cow Diagnosis Treatment 40 Lac Loxin 10ml Dialy
- ⌚ 31.10.2023 Pseudomonas Aeruginosa Identification And Laboratory Diagnosis (English) - Medical Microbiology
- ⌚ 20.12.2023 Субботняя распаковка для диагностов #7. MB Star Diagnosis C4
- ⌚ 10.11.2023 Процесс клина видео Diagnosis от A_kaeyada
- ⌚ 02.05.2024 Leptospirosis: Microbiology, Diagnosis, Treatment, & Prevention
- ⌚ 05.02.2025 Прохождение нового Эпизода // Diagnosis: Multitude 1.3
- ⌚ 26.01.2025 3.04 Shock- Sources & Diagnosis
- ⌚ 15.11.2023 Breast Cancer Diagnosis And Prevention
- ⌚ 04.03.2024 Vibration Diagnosis Tools - The NVH App
- ⌚ 30.06.2024 Alcoholism - Causes, Symptoms, Diagnosis, Treatment, Pathology The Truth About Addiction Adam Jabli
- ⌚ 22.01.2024 XENTRY Diagnosis Kit 3 RUS HD
- ⌚ 27.01.2025 10 Hypothyroidism- Symptoms, Diagnosis & Treatment
- ⌚ 25.03.2022 Pneumothorax - Causes, Symptoms, Diagnosis, Treatment, Pathology.mp4
- ⌚ 26.08.2024 ПРОХОЖДЕНИЕ DIAGNOSIS: MULTITUDE!!!!
- ⌚ 22.08.2023 LG 6motion - Smart Diagnosis Tutorial
- ⌚ 12.02.2026 05 - Diagnosis (Tristania)
- ⌚ 27.08.2023 LG Refrigerator With Smart Diagnosis
- ⌚ 19.10.2024 Maserati Quattroporte (2005) Full Diagnosis
- ⌚ 20.04.2026 БОЛГАРИЯ - ПОБЕДА ЕВРОСКЕПТИКОВ/ БОНЯПАРТ//ТАРАС СИДОРЕЦ
- ⌚ 03.12.2024 Без ЭТОГО Витамина Ждите Гипотиреоз, Узлы в Щитовидке, Ожирение и еще 37 Болезней! Ольга Лисенкова
- ⌚ 30.01.2025 DeWalt DW735 Planer: Motor Disassembly & Diagnosis
- ⌚ 07.02.2024 Carman Scan VG+ - Diagnosis
- ⌚ 30.11.2023 BMW E46 Diagnosis ISTA
- ⌚ 01.10.2023 Kawasaki Zx6r J1 Stuttering Problem Diagnosis
- ⌚ 23.01.2024 Audi 2.7t P1557 Diagnosis
- ⌚ 20.09.2024 NT10A Noise Tester Overview And NVH Diagnosis
- ⌚ 06.12.2024 Fuel Pressure Regulator Diagnosis + Understanding HD!!
- ⌚ 04.02.2025 2.06 Hemorrhagic Shock- Diagnosis
- ⌚ 16.04.2024 Diagnosis: Surprise ~ Mlp Creepypasta (22 часть)
- ⌚ 24.02.2025 Diagnosis: Surprise ~ Mlp Creepypasta (19 часть)
- ⌚ 27.01.2025 04 Hyperglycemia- Diagnosis & Management
- ⌚ 28.08.2023 Bosch E28 Error Code Diagnosis And Repair
- ⌚ 27.02.2025 XENTRY Diagnosis VCI Or SDconnect
- ⌚ 22.08.2024 Наше оборудование. Star Diagnosis, Launch, I Com, Вася диагност. Сканеры.
- ⌚ 20.02.2024 Dell P2723QE Diagnosis Full
- ⌚ 04.11.2010 Michelle Clunie In "Diagnosis Murder"
- ⌚ 18.03.2025 Rapid And Accurate Diagnosis 2014 Mervyn Singer
- ⌚ 02.10.2023 Austin Rover - Service Insight - Electric And Electronic System Diagnosis (1986)
- ⌚ 01.03.2024 Mitsubishi Fuso Diagnosis Taller Pikyoeautomocion Mitsubishi Fuso Canter SAM Diagnosis
- ⌚ 20.10.2024 Pioneer CT 7100 Bias Trap - Diagnosis And Repair
- ⌚ 05.01.2026 Diagnosis Multitude Gameplay .mp4
- ⌚ 13.01.2025 R34 ATTESA Self Diagnosis Without Consult
- ⌚ 04.09.2025 Dell D531 Star Diagnosis








![[LG ThinQ] Refrigerator Smart Diagnosis](https://pic.rtbcdn.ru/video/bf/70/bf7062f2ea90ddf39332e87be3911fec.jpg)



























![D03_[General Differential Diagnosis]](https://pic.rtbcdn.ru/video/2025-01-03/b7/97/b797bc031cdd45a5b72e4e52b8edc2d7.jpg)